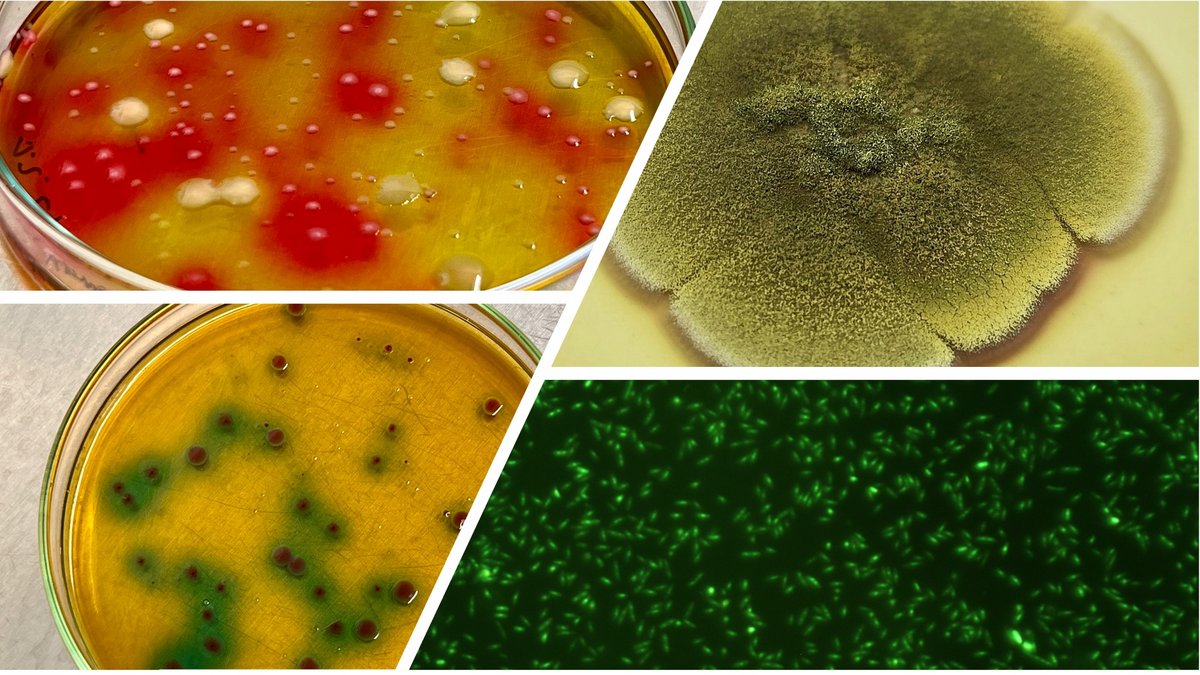

Der Lehrstuhl Biotechnologie der Wasseraufbereitung ist Teil der Fakultät 2 - "Umwelt- und Naturwissenschaften". Zusammen mit den Fachgebieten "Gewässerökologie", "Hydrologie" sowie "Wassertechnik und Siedlungswasserbau" bildet er den Lehrkomplex "Wasser". Die vier Fachgebiete des Komplex "Wasser" vermitteln gemeinsam mit den Komplexen "Boden" und "Luft" im Bachelorstudium für die Studierenden des Umweltingenieurswesen naturwissenschaftliche und technische Grundlagen. Im Masterstudium für Umweltingenieure werden weiterführende Vertiefungsvorlesungen angeboten. Weiterhin bietet der Lehrstuhl Lehrveranstaltungen für Bauingenieure und Wirtschaftingenieure an.